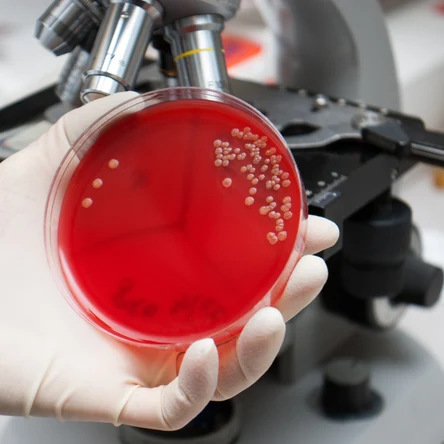
Биологические исследования

Лабораторные исследования
Лабораторные исследования для экологии и производственного контроля
По умолчанию
500 ₽/пробаРадиационный контрольИзмерение показателей радиационного контроля (объемной активности и плотности потока радона, мощности гамма-излучения) на земельных участка и в зданиях и помещениях, количественный радиохимический анализ (определение удельной активности) радионуклидов в почве, воде, воздухе